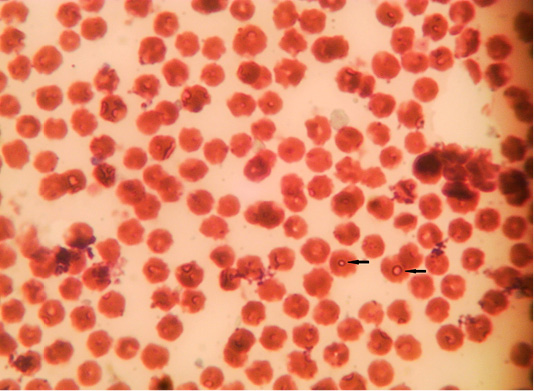

Advances in Animal and Veterinary Sciences
Microphotograph showing intra-erythrocytic merozoits of sheep blood smears (Field stain, x100).
Microphotograph showing intra-erythrocytic merozoits of sheep blood smears (Field stain, x100).
Microphotograph showing lymphocytic microschizont of sheep blood smears (Field stain, x100).
Microphotograph showing lymphocytic macroschizonts (Koch’s blue bodies) of lymph nodes smears (Field stain, x100).
Ethidium bromide stained gel electrophoresis showing specific bands from PCR amplified products by using Theileria spp. universal primer in lane 3,6 and 10. Lane M: marker 100 bp.
Ethidium bromide stained gel electrophoresis showing specific bands from PCR amplified products by using T. ovis specific primer in lane 1, 2, 3, 4, 5, 6, 7, 8, 10 and 11. Lane M: marker 100 bp.
Ethidium bromide stained gel electrophoresis showing specific bands from PCR amplified products by using T. lestoquardi specific primer in lane 6, 8, 9 and 10. Lane M: marker 100 bp.
Macrophotograph of lymph node showing enlargement and sub-capsular hemorrhages.
Macrophotograph of spleen showing splenomegaly and sub-capsular hemorrhages.
Microphotograph of sheep spleen showing (A) diffuse hemorrhage with deposition of brownish hemosiderin pigment in addition to necrotic foci and diffuse depletion of the lymphoid tissue (H and E, x200) and (B) diffuse deposition of bluish hemosiderin pigment (Prussian blue, x200).
Microphotograph of sheep lymph node showing depletion and necrosis of multiple lymphoid follicles (arrows) (H and E, x200).
Phylogenetic tree of T. lestoquardi (MT002826) revealed 100% homology with T. lestoquardi from (KF771185), (KM117212 and KJ458988), (AF081135) and (KC778786). This isolate showed 99% homology with T. annulata from (KF429799), (AY508463), (MG599090) and (DQ287944).
Phylogenetic tree of T. ovis (MT002827) revealed 98% homology with T. ovis from (MG203885), (EU622911), (KT851436), (FJ603460), (MG725961) and (MH819508).